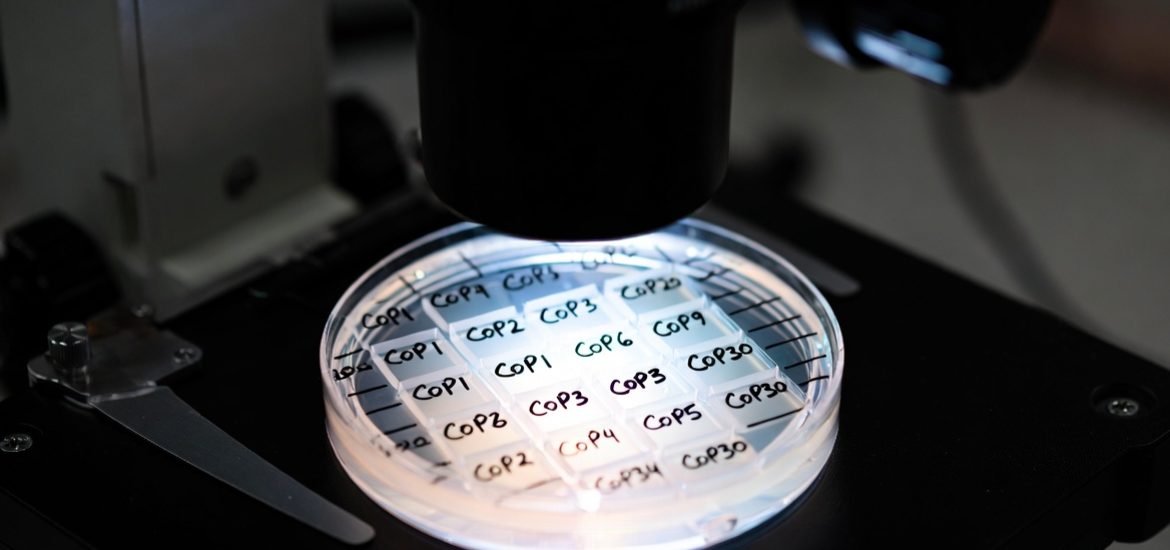
30 ans de COP au microscope, à la recherche de résultats

Ingénieur, docteur en Sciences appliquées, avec plus de 36 ans d’expérience à la direction générale de l’énergie de la Commission Européenne, auteur d’une vingtaine d’ouvrages sur l’énergie, il fallait bien le pedigree de Samuel Furfari pour écrire un ouvrage tel que « La vérité sur les COP, trente ans d’illusions ». Qui d’autre peut oser exercer son esprit critique au sujet de ces vaches sacrées que sont les Conférences des parties et poser légitimement la question de leur utilité (1).
Questions qui dérangent
Dans ce nouvel opus, Furfari qui est aussi professeur à l’ULB et à l’ESCP, remonte patiemment à l’origine de ces réunions et année après année, ou presque, fait le bilan en donnant des éléments sur l’organisation et parfois avec force détail : « combien ça a coûté », « qui a participé », « quels moyens ont été mis en oeuvre »… ou encore, on ose à peine – et pourtant ça compte – « qui est venu en jet privé ? » et « qui a payé ? ». Des éléments qui pour certains relèvent de l’accessoire… Qu’ils se rassurent car l’auteur n’oublie pas l’essentiel : « quels accords ont été conclus », « ont-ils été respectés », et si c’est le cas, par qui, « comment, dans quelles conditions et pour combien de temps ? »
Bref, si vous vous dites qu’il est tout de même étrange que les COP, après 30 ans d’existence, n’aient jamais été auditées, avec la vérité sur les COP de Samuel Furfari c’est chose faite, ou presque, sachant qu’il ne s’agit pas d’un travail exhaustif, mais du « témoignage d’un acteur-observateur »(2) qui relate les événements auxquels il a participé activement pour plusieurs et a ensuite toujours suivi les autres en tant que spécialiste de l’énergie (3).
Moines COPistes
La plongée dans l’univers « COPiste » commence donc avec un retour sur les ambitions de « gouvernance planétaire » du Club de Rome, véritable matrice intellectuelle avec son rapport Limit to growth, qui comme on le sait, pose la question d’une « croissance infinie dans un monde fini » et aussi The First Global Revolution (1991) ouvrage dans lequel on peut lire « le véritable ennemi est donc l’humanité elle-même. » (sic !). Ces racines intellectuelles ont donné lieu à un mouvement global qui s’est concrétisé lors de la première conférence mondiale sur l’environnement à Stockholm en 1972. Furfari rappelle le rôle fondamental joué par certains acteurs tels que le mystérieux Maurice Strong ou encore, Gro Harlem Bruntland, l’ancienne première ministre norvégienne, fer de lance du projet de gouvernance mondiale.
Outre ces personnalités hors du commun, les ONG en sapant les fondements démocratiques des souverainetés nationales ont permis l’émergence d’une « gouvernance technocratique ». Furfari décrit bien les différents événements qui ont permis l’émergence de la CCNUCC (Convention Cadre des Nations-Unies sur les changements climatiques), cadre des COP, événements annuels lors desquels les Etats s’engagent à publier leurs inventaires d’émissions de GES, les stratégies nationales pour les faire diminuer, et une coopération dans « la recherche, le développement et le transfert de technologies propres »… Tous ces objectifs, comme le rappelle l’auteur, étant non contraignants. Commentaire qui revêt une importance fondamentale au regard du bilan de ces événements, comme on le verra. A toutes ces considérations, l’ «ingénieur-pasteur » attire notre attention sur le glissement idéologique vers une forme de néo-paganisme : « la nature est redevenue une divinité, un objet de vénération quasi sacrale, entourée d’interdits modernes, dont les fidèles, désormais les « sectateurs » d’une nouvelle religion climatique, semblent prêts à tout pour calmer sa supposée colère. »
De la COP1 à la COP26 : le bel exercice de communication
Ces considérations théoriques passées, l’ancien fonctionnaire européen rentre dans le vif du sujet et nous fait part de ses souvenirs des premières COP : la COP1 de Berlin, lors de laquelle l’Allemagne, sous la présidence de Merkel, s’affirme comme un « moteur idéologique » et la COP2 de Genève où l’ambassadeur US, Daniel L. Spiegel revendique (déjà ?) la souveraineté US en prononçant une phrase qui a marqué l’auteur « You are not going to decide the size of the refrigerators of the US citizens »
Lors de la COP3 en 94, à Kyoto – un des événements les plus marquant – Furfari est en charge du dossier du changement climatique à la direction générale de la Commission Européenne. Il fait donc bénéficier à ses lecteurs d’un témoignage direct de l’histoire. Comme on le sait, cette COP marque un tournant, car elle a donné lieu à la signature du protocole de Kyoto. Or si celui-ci semble représenter une victoire pour les activistes, les résultats sont mitigés car, « non contraignants ». Les USA des démocrates Bill Clinton et Al Gore n’ont pas ratifié le traité.
Autre point négatif : « le manque de transparence » une caractéristique qui est propre à la logique des COP nous dit le professeur : « plutôt que de s’arrêter pour dresser un bilan honnête des engagements passés, la dynamique des COP consiste à avancer sans relâche, à fixer sans cesse de nouveaux objectifs, souvent plus contraignants, sans jamais s’interroger sur l’efficacité des mesures déjà prises. »
Dans le cas de l’UE, le protocole semble avoir fait preuve d’efficacité, mais si on regarde de près les raisons qui ont causé les baisses d’émissions, c’est essentiellement dû, comme le montre l’ingénieur, à des facteurs structurels (élargissement à l’Est, modernisation) et conjoncturels (crise des subprimes). Tous les pays européens ne sont pas à la même enseigne, comme en témoigne la lettre d’un Prodi (alors président du Conseil Italien) mécontent, à laquelle l’auteur a eu accès et qu’il nous livre en exclusivité.
La richesse de l’ouvrage est inestimable, Furfari a une anecdote ou un commentaire pour de nombreuses COP, ce qui donne sa valeur à l’ouvrage pour les historiens qui travailleront demain sur le sujet.
La COP6 organisée à La Haye est un tel échec que les négociations ont été ajournées et reprises quelques mois plus tard à Berlin, lors d’une « COP6 bis » où un compromis a été trouvé moyennant des efforts inouïs de communication. Côté anecdote, l’ancien fonctionnaire européen nous raconte sa collaboration avec Loyola de Palacio, vice-présidente de la Commission européenne (qui a reçu des ONG environnementale le prix de destructrice du climat), au sujet d’un livre vert dont les grandes lignes consistent à défendre la diversité des énergies. Une thèse qui ne l’a hélas pas emporté face à l’Energiewende allemande.
La COP15 de Copenhague est un fiasco total à cause de nombreux affrontements diplomatiques.
La COP19, organisée à Varsovie est la première d’une trilogie de ce que Furfari appelle les « COP du charbon », sachant que la Pologne est le plus gros consommateur européen et qu’elle tient à organiser ses événements pour peser sur l’échiquier politique.
Quand on compare le traitement médiatique habituel réservé à la COP21 et que l’on découvre le témoignage de Furfari qui parle de « désaccord de Paris » on se demande qui dit la vérité. Et pourtant malgré les tapages médiatiques et quand on lit entre les lignes on découvre que « les pays ne promettent pas fermement de ne pas dépasser 1,5°C ; ils s’engagent simplement à poursuivre des efforts. » Il a fallu donc tout l’engagement des activistes pour masquer cette nuance de taille qui fait que chacun fait ce qu’il veut (voir le tableau de la page 155) en prenant comme année de référence celle qui l’arrange le plus ; hormis peut-être l’UE qui joue les bons élèves et prend l’accord comme un engagement formel et non un cadre général.
La COP24 est une fois de plus en Pologne et l’occasion de découvrir un nouveau talent de l’auteur : un côté pince sans rire (3). Autres faits marquants pour Katowice, la participation officielle de Greta Thunberg et l’édition d’un « Rule book » histoire de « transformer une urgence planétaire en festival de paperasse ». Enfin, pour ceux qui l’auraient oublié, Emmanuel Macron y est venu faire de grands discours tandis qu’au niveau national il reculait face aux gilets jaunes.
Lente descente aux enfers
La COP26 organisée au Royaume Unis marque un tournant. Outre le fait que Boris Johnson ait fait son coming out écologiste, le sommet a laissé se dégager un schisme de plus en plus apparent entre l’UE donneuse de leçon et le reste du monde plus réaliste et convaincu de la nécessité d’une transition progressive. Alors que les Anglais souhaitaient une disparition totale du charbon (phase out), les pays tels que l’Inde et la Chine ont dit « pas question ».
A l’issue de cette COP, les suivantes – baptisées « COP des pétrodollars » par l’auteur – n’ont été qu’une longue descente aux enfers pour les organisateurs et les militants : organisées respectivement à Charm el-Cheikh, à Dubaï et à Bakou, on y a caractérisé les objectifs climatiques d’utopie, on y a réintroduit le nucléaire et les énergies fossiles et les ONG y ont trouvé de nombreux obstacles sur leurs routes.
Dans les deux derniers chapitres de l’ouvrage, l’auteur, sort du simple témoignage pour rentrer dans le jugement de valeur, étayé par de nombreuses informations. Il constate que « l’Afrique en a assez des COP » car ses populations victimes de la pauvreté énergétique ont bien d’autres préoccupations que le rationnement imposé par les transitions énergétiques inspirées par l’Energiewende.
Enfin, en conclusion, vient le bilan tant attendu et annoncé dans un « Tout ça pour ça » avec cet extrait qui dit tout : « Entre 1990 et 2024, les émissions mondiales de CO2 liés à l’énergie ont augmenté de 66 %(…) Ce constat quantitatif met en lumière l’écart persistant entre les objectifs climatiques, affichés et la réalité de la consommation énergétique mondiale. »
On a atteint le point d’orgue de l’ouvrage. Le bilan des COP est bien maigre. Un fait qui devrait interpeller tous les citoyens et les militants des ONG en premier. Car si, malgré tous ces efforts, la gouvernance mondiale n’arrive pas à se mettre d’accord pour le climat, c’est, soit que les objectifs sont mal définis, soit que les moyens pour les atteindre ne sont pas bons. A la lecture de l’ouvrage on comprend que les deux arguments sont également valables.
« The final COP down »
Voici donc un livre salutaire pour le citoyen qui veut s’informer et questionner la politique scientifique mise en place au sujet du climat et, sans remettre en cause la thèse du changement climatique, questionner les moyens mis en oeuvre pour y faire face. En lisant la Vérité sur les COP, on s’interroge sur l’efficacité supposée de cette tentative de mise en place d’une gouvernance mondiale – d’une Climatocratie (5)- et éventuellement remettre en cause son utilité. Car au final c’est bien le citoyen contribuable qui paye tous ces frais (de bouche) et il a le droit de savoir ce que ça lui rapporte. D’aucun diront que la fin justifie les moyens. Trop de fois cette maxime a montré au travers de l’histoire qu’elle permettait de cautionner les pires erreurs de jugements. N’est-il pas normal de s’interroger sur combien les 66708 participants à la COP de Bakou (en présentiel et en virtuel) ont coûté et qu’ont-ils obtenu comme résultats ? Bien évidemment on trouvera toujours des fortes têtes qui ne souhaitent pas que l’on pose ce genre de question et qui voudraient même faire taire ceux qui osent la poser sous prétexte de maintenir le consensus. Mais alors qu’ils ne prétendent pas vouloir absolument régler la problématique du climat, car dans 30 ans et au rythme d’une nouvelle COP par an, on peut très bien imaginer des événements à 130000 participants tandis que les émissions auraient progressé de 132% d’émission de CO2 depuis 1990.
Merci au professeur Furfari d’avoir regardé de près avec toute son expertise ce qui se tramait exactement derrière les COP… et découvert la taille microscopique des résultats.
(1) Précisons d’emblée qu’il ne s’agit pas d’un énième ouvrage sur la science du climat… Le pasteur-ingénieur Furfari remarque au passage que ce débat a beaucoup en commun avec le Filioque, débat qui occupait la chrétienté pour qualifier la procession du Saint Esprit.
(2) A noter également une préface de Carlo Ripa Di Mena, un ancien commissaire européen, figure de l’écologisme qui nous offre son mea-culpa en introduction et avoue s’être trompé.
(3) Au passage, on appréciera les quelques tableaux récapitulatifs très instructifs : la liste des COP depuis 1995 jusqu’à 2030, le nombre de participants aux COP, ou encore le classement des consommateurs d’énergie primaire, pour n’en citer que quelques-uns..
(4) « L’histoire retiendra que la COP27 censée sauver la planète à coup de résolution, lyrique, a surtout brillé par la taille pantagruéliques de ces délégation. Il ne s’agit plus d’une simple réunion de quartier, mais d’un sommet ou plus de 7868 participants se sont pressés à Katowice. » Nous dit Furfari avec plus de 426 représentant pour la Guinée (voir le tableau détaillé p.179)
(5) Jean-Paul Oury, Greta a ressuscité Einstein ( VA édition, 2022 )
A lire
En souvenir de Loic Le Floch-Prigent, un homme de raison au service de l’industrie
Une pétrochimie européenne plus vertueuse grâce au gaz de schiste US ?
Un pays peut-il laisser la production de son énergie électrique en des mains étrangères ?

Je cite « la nature est redevenue une divinité, un objet de vénération quasi sacrale, entourée d’interdits modernes, dont les fidèles, désormais les « sectateurs » d’une nouvelle religion climatique, semblent prêts à tout pour calmer sa supposée colère. » Tout est dit er c’est aussi mon avis. L’écologisme est devenue une religion d’état au même titre que le capitalisme, le marxisme ou le nationalisme. Alors que l’écologie doit rester un moyen de sauver la biodiversité et donc l’espèce humaine. Avec en plus une référence au tube du groupe suèdois Europ « the final COP down » ! Le compte à rebours est déclenché…
Un article qui devrait faire réfléchir les Sapiens de bonne volonté pour « un saut majeur de conscience ».